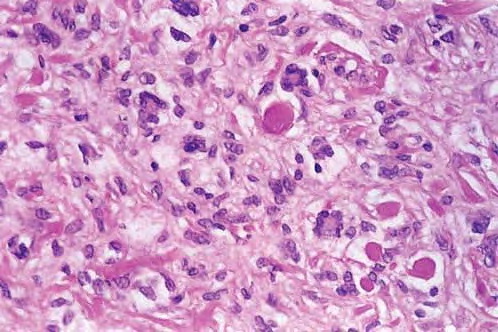

Darier =داء داريير
Darier =داء داريير Dariers Disease Darier’s disease is usually transmitted in an autosomal dominant pattern. It has been found to be due to mutations in the ATP2A2 gene on chromosome T2, which encodes the sarcoplasmic/endoplasmic reticulum calcium pumping ATPase SERCA2 (206). The gene is 12q23-24.1. In typical cases, there is a more or less […]
Read More